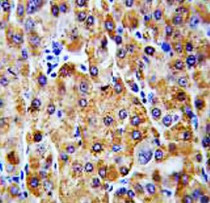

ARG54836
anti-CBS antibody
anti-CBS antibody for Flow cytometry,ICC/IF,IHC-Formalin-fixed paraffin-embedded sections,Western blot and Human,Mouse
Cancer antibody; Metabolism antibody; Signaling Transduction antibody
概述
| 产品描述 | Rabbit Polyclonal antibody recognizes CBS |
|---|---|
| 反应物种 | Hu, Ms |
| 应用 | FACS, ICC/IF, IHC-P, WB |
| 宿主 | Rabbit |
| 克隆 | Polyclonal |
| 同位型 | IgG |
| 靶点名称 | CBS |
| 抗原物种 | Human |
| 抗原 | KLH-conjugated synthetic peptide corresponding to aa. 104-133 (N-terminus) of Human CBS. |
| 偶联标记 | Un-conjugated |
| 別名 | Serine sulfhydrase; Beta-thionase; AI047524; EC 4.2.1.22; Cystathionine beta-synthase; HIP4; AI303044 |
应用说明
| 应用建议 |
|
||||||||||
|---|---|---|---|---|---|---|---|---|---|---|---|
| 应用说明 | * The dilutions indicate recommended starting dilutions and the optimal dilutions or concentrations should be determined by the scientist. | ||||||||||
| 阳性对照 | Ramos |
属性
| 形式 | Liquid |
|---|---|
| 纯化 | Purification with Protein A and immunogen peptide. |
| 缓冲液 | PBS and 0.09% (W/V) Sodium azide |
| 抗菌剂 | 0.09% (W/V) Sodium azide |
| 存放说明 | For continuous use, store undiluted antibody at 2-8°C for up to a week. For long-term storage, aliquot and store at -20°C or below. Storage in frost free freezers is not recommended. Avoid repeated freeze/thaw cycles. Suggest spin the vial prior to opening. The antibody solution should be gently mixed before use. |
| 注意事项 | For laboratory research only, not for drug, diagnostic or other use. |
生物信息
| 数据库连接 | |
|---|---|
| 基因名称 | CBS |
| 全名 | cystathionine-beta-synthase |
| 背景介绍 | The protein encoded by this gene acts as a homotetramer to catalyze the conversion of homocysteine to cystathionine, the first step in the transsulfuration pathway. The encoded protein is allosterically activated by adenosyl-methionine and uses pyridoxal phosphate as a cofactor. Defects in this gene can cause cystathionine beta-synthase deficiency (CBSD), which can lead to homocystinuria. Multiple alternatively spliced transcript variants have been found for this gene. [provided by RefSeq, May 2010] |
| 生物功能 | Only known pyridoxal phosphate-dependent enzyme that contains heme. Important regulator of hydrogen sulfide, especially in the brain, utilizing cysteine instead of serine to catalyze the formation of hydrogen sulfide. Hydrogen sulfide is a gastratransmitter with signaling and cytoprotective effects such as acting as a neuromodulator in the brain to protect neurons against hypoxic injury (By similarity). [UniProt] |
| 细胞定位 | Cytoplasm. Nucleus |
| 研究领域 | Cancer antibody; Metabolism antibody; Signaling Transduction antibody |
| 预测分子量 | 61 kDa |
检测图片 (4) Click the Picture to Zoom In
-
ARG54836 anti-CBS antibody ICC/IF image
Immunofluorescence: 293 cells stained with ARG54836 anti-CBS antibody (green). Actin filaments have been labeled with Alexa Fluor 555 phalloidin (red). DAPI (blue) for nuclear staining.
-
ARG54836 anti-CBS antibody IHC-P image
Immunohistochemistry: Formalin-fixed and paraffin-embedded Human hepatocarcinoma stained with ARG54836 anti-CBS antibody.
-
ARG54836 anti-CBS antibody WB image
Western blot: 35 µg of Ramos cell lysate stained with ARG54836 anti-CBS antibody.
-
ARG54836 anti-CBS antibody FACS image
Flow Cytometry: Ramos cells stained with ARG54836 anti-CBS antibody (bottom histogram) or without primary antibody control (top histogram), followed by incubation with FITC labelled secondary antibody.